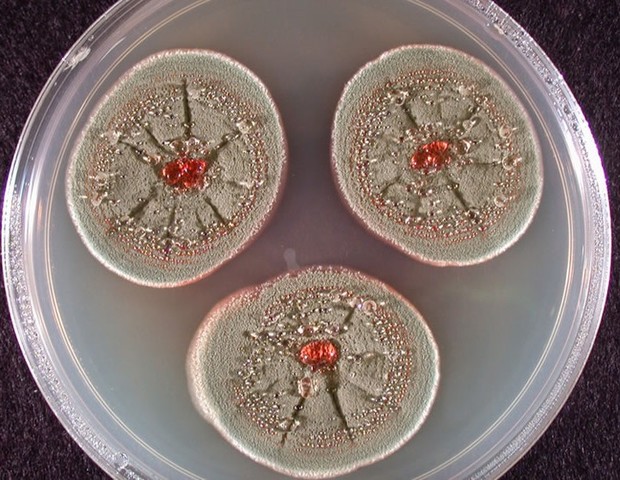
Descubrimiento de la penicilina
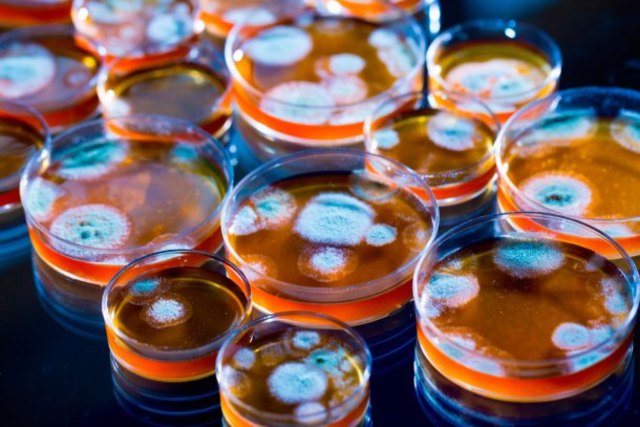
Cultivos de penicilina

-
-
-
Descubrimiento de diferentes variedades de cobre
-
-
-
-
Implementación de metales para la guerra
-
Descrubrio la electricidad estática, predijo un eclipse y fue autor de una cosmologia en la que dice que el agua es el eje de todo.
-
Se desarrolla la primera Teoría Química
-
Considerado el primer matemático puro, contribuyo en la aplicación de las matemáticas en teorías de peso y medidas.
-
Aire elemento contribuyente del universo
-
Teoría de los 4 elementos.
-
Desarrolló la teoría atómica del universo
-
La realidad está formada tanto por partículas infinitas, indivisibles, de formas variadas y siempre en movimiento, los átomos, como por el vacío.
-
Influyo sobre la teoría atómica, y la ataraxia, al hacerlas parte de su filosofia
-
Desarrollo en el nombre de la quimica
-
Primera teoría de la transmutación de los elementos.
-
Escribió libros sobre los átomos y y el vació, en forma de poemas.
-
Libro de alquimia usado en Egipto donde describe la etimología de la química
-
Aristoteles propuso la teoría geocentríca. También dijo que todo esta conformado por cuatro elementos, que son fuego, agua, tierra y aire. Y el peso de cada cuerpo está determinado por la proporción que contiene de cada uno de ellos.
-
Se descubrieron libros de Alquimia que influyeron sobre el interés en esta y una de las razones de su crecimiento.
-
Alcohol, alambique, álcali, garrafa, narta y circón
-
Se desarrolló una clase de fuego en Grecia que no se podía apagar con agua.
-
Escritos para el avance de la quimica
-
Origen aspectos médicos de la Alquimia
-
Escribió un libro donde se describe la orfebrería
-
Inicia el estudio de los diferentes seres que habitan en el mundo
-
Primer alquimista europeo
-
Aplicación de las técnicas matemáticas en la ciencia.
-
Inicia el interés en la transmutación de las personas.
-
Escritos sobre el ácido sulfúrico y descripción de sustancias como agua, aire, carbón y petroleo.
-
Se desarrolla la Pólvora negra
-
Copernico da la teoría heliocéntrica después de Aristarco de Samos.
-
Se halla un libro de metalurgia donde están sus características principales y su historia.
-
Progenitor de la anatomía humana.
-
Libro descriptivo “Una alquimia“
-
Aplicación de las matemáticas
-
El volumen disminuía a medida que aumentaba la presión
-
Comprobó que el aire ejercía presión
-
Se estudian las propiedades del fuego para nuevas utilidades
-
Demostró la fuerza de la atmósfera
-
Libro sobre usos médicos del antimonio y sus derivados.
-
Imaginó que los sólidos estaban hechos de 3 tipos de tierra
-
Establece que la presión de un gas en un recipiente cerrado es inversamente proporcional al volumen del recipiente, cuando la temperatura es constante.
-
Se preparao fósforo a partir de orina
-
Conclusiones sobre las Matemáticas
-
Se le pidió al Gobierno Británico que aboliese la ley contra la fabricación alquimista de oro
-
Construyó una Máquina de Vapor
-
Se acepta oficialmente y se denomina a la alquimia como Quimica
-
Descubrimiento de nuevos elementos para la tabla periódica
-
Teoria de Gases sobre el Agua
-
Descubrió el cobalto
-
Explica como una sustancia reacciona con otra
-
Intentaron medir el oxígeno y dióxido de carbono
-
Joseph Black postula la teoría del Aire Fijo
-
Los carbonatos se conviertan en alcalinos
-
Formación de metales a trávez de la combinación del metal y el gas
-
Descubridor del oxígeno
-
Midió el peso de volúmenes de diferentes gases
-
-
Desarrollado por Morveau, Berthollet, Fourcroy y lavoisier para el ordenamiento y clasificación de los elementos y sustancias quimicas
-
Descubrió el óxido metálico
-
Descubre el berilio
-
-
Vitaminas, hormonas y alcaloides
-
Se comprobó que la ley de proust era verdadera
-
-
-
El progreso más espectacular se operó en los metales.
-
Se ideo una técnica para producir económicamente el acero.
-
Publicación por parte de Dalton en 1803
-
Se descubre el aceite de oliva y el azúcar
-
Propone el nombre de luz polarizada
-
Gay-Lussac dio a conocer la ley de volúmenes de combinación en 1808.
-
Se dieron las formulas empiricas de los azucares simples
-
Establece que "una cantidad de cualquier tipo de gas, en un mismo volumen, a la misma temperatura y la misma presión, contiene el mismo número de moléculas, independientemente del tipo de gas que sea".
-
Se produce la Glucosa a partir del almidón
La glucosa es azúcar que se encuentra en la miel, la fruta y la sangre de los animales. -
Experimenta sus prismas
-
Pertenece al dominio de la física
-
Es uno de los aminoácidos que forman las proteínas de los seres vivos.
-
Estudio de los compuestos.
-
John Walker ideo la primera cerilla de fósforo practica.
-
Demuestra que el aluminio es un metal.
-
Berzelius hizo la primera tabla de pesos atomico
-
Se dio la definición de la química organica
-
Se desarrollan las formula empíricas más confiables para datos más exactos.
-
Establece que las velocidades de difusión y efusión de los gases son inversamente proporcionales a las raíces cuadradas de sus respectivas masas molares.
-
Sustituyó el cloro en el lugar ocupado por tres átomos de hidrógeno en el ácido acético
-
El "Hemo" es un grupo prostético que forma parte de diversas proteínas.
-
Se utiliza por su potente propiedad vasodilatadora en hipertensión. Es útil en situaciones agudas, como el tratamiento de una crisis anginosa. Posee la capacidad de relajar las arterias y venas periféricas reduciendo el gasto cardíaco y el consumo de oxígeno por el músculo del corazón.
-
Gana popularidad la teoría de Laurent la cual generaliza la noción de función y la de medida.
-
Descubrió, estudió y nombró las aminas
-
Primer indicio de comprensión de actividad optica
-
Se sintetizan los productos orgánicos.
-
Probó que las líneas espectrales se trataban de un elemento y este era metal al calino y rabidio
-
Demuestra que la familia éteres podía formarse según el tipo de agua
-
Se desarrolla la Triestearina, base de la producción del jabón
-
Elaboró un método para preparar el aluminio en cantidades modernas.
-
Predomina el color purpura por su hallazgo
-
Elaboró estructura de las moléculas orgánicas más simples
-
Edwin Laurentine, perforador de petróleo de los Estados Unidos, se le atribuye popularmente el haber descubierto el petróleo.
-
Explicó la existencia de isomeros
-
Ordenó los elementos según su peso atómico
-
August kekulé descubre los anillos del carbono
-
Halló que los elementos conocidos contenían solamente el 93% de su peso
-
Es una roca sedimentaria silícea formada por micro-fósiles de diatomeas, que son algas marinas unicelulares que secretan un esqueleto silíceo llamado frústula.
-
-
Teoria de las tensiones
-
Estructura de la clorofila.
-
elaboracion de ecuación que relacionaba el volumen y la temperatura de los gases
-
Sugirió que los cuatro enlaces de carbono estaban distribuidas en las tres dimensiones del espacio
-
Descubrió el galio
-
El físico ingles William crookes ideo un tubo con un vació mas perfecto que permitía estudiar con mas facilidad el paso de la corriente eléctrica.
-
Descubrió el disprosio
-
El físico alemán Eu-gen Goldstein detecto los protones en el tubo de rayos catodicos.
-
El físico americano Josiah Willard contribuyo en una serie de trabajos sobre leyes de termodinamica
-
Descubrió la samaria
-
Organizó diferentes compuestos dentro de un orden racional
-
Estructura hemo
-
Aleacion de Hadfield
-
Representa dibujos átomos de carbono fijos a anillos planos
-
Halló que el dimio era una mezcla de dos elemto
-
Aisló el fluor
-
Encontró el neón, krypton y xenon
-
Marie Sklodowska Curie la primera mujer científica descubrió que el torio es un metal radiactivo
-
Investigo compuestos orgánicos que contenían el silicio.
-
Estructura molecular en tres dimensiones
-
Descubrió que los compuestos de uranio puro recién preparados eran solo débilmente radioactivos
-
Se reveló una extensa frontera entre la química orgánica e inorgánica.
-
Ideó un equipo capaz de conseguir presiones más altas.
-
Albert Einstein creo una ecuación para calcular el tamaño real de las moléculas de agua
-
Se utilizo mucho el dibujo en tinta sobre pergamino.
-
Descubrió el lutecio
-
-
Halló que podían formarse compuestos complicados.
-
Se fundo la quimioterapia
-
-
-
Fritz Pregl desarrolló las técnicas de Microanálisis
-
Descubrió un imán más potente que el acero.
-
Patentó el acero inoxidable.
-
demostró que las partículas alfa podían arrancar los protones de los núcleos de nitrógeno, y fusionarse lo que quedaba
-
-
Aporto razones teóricas para considerar que los electrones poseían electrones poseían propiedades de características de una onda
-
La celulosa es un material plástico de nitrato de celulosa, y fue utilizado por primera vez ampliamente como sustituto del marfil. El principal uso fue en las industrias del cine y la fotografía, que utilizaron únicamente películas de celuloide antes de que las películas de acetato fueran introducidas
-
Se inicia el estudio y desarrollo de la electroforesis para su uso
-
Se descubre por accidente la penicilina
-
Diseñaron el primer acelerador, capaz de producir una reaccion quimica
-
Preparó el freón con una molécula que consistía en un átomo de carbono.
-
Diseño el acelerador que obligaba las partículas a moverse, según el espiral que se ampliaba lentamente
-
-
El ingles James Chadwick descubrió una partícula que tenia la misma masa que el proton, pero que no poseía ninguna carga eléctrica, a esta la denomino Neutron.
-
Bombardeo neutronico del uranio, detectaron un nuevo tipo de atomo
-
-
Se empiezan los cultivos de la penicilina en la Primera Guerra Mundial
-
Colesterol y sintetizacion de la reserpina
-
-
-
-
Con las técnicas de Brigma se producieron diamantes sintéticos.
-
Woodward
-
-
Woodward sintetizo la acromicina
-
Obtuvo muestras de un gas